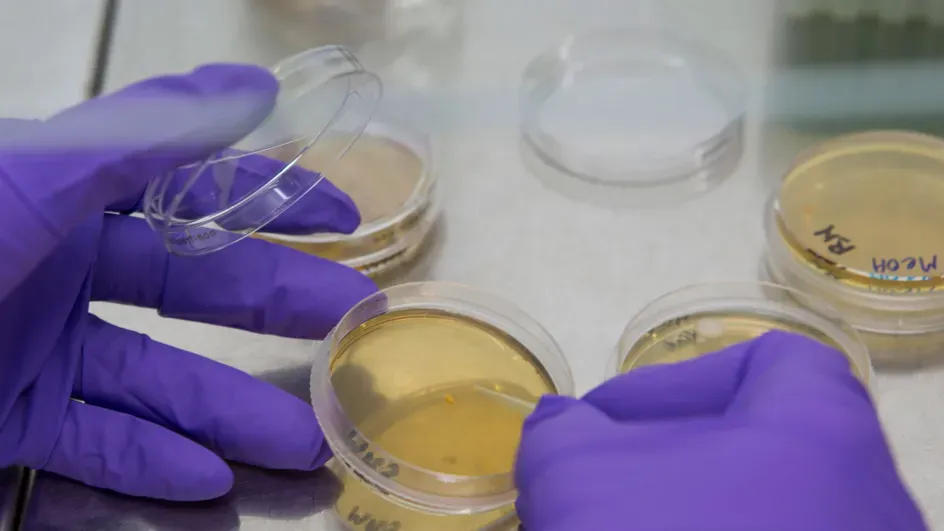

Kew Science
Our purpose is to help stop biodiversity loss and develop nature-based solutions to some of humanity’s biggest global challenges.

With over 580 science staff, Kew’s mission is to understand and protect plants and fungi for the well-being of people and the future of all life on Earth.
Sign up to the Kew Science monthly newsletter
Stay up-to-date with Kew’s plant and fungal research news, science events and scientific opportunities.
State of the World's Plants and Fungi 2023 report
A massive collaboration from 200 scientists across 100 institutions and 30 countries.
Read & watch
Our collections, resources and facilities

Collections
With over 8.5 million items, Kew houses the largest and most diverse botanical and mycological collections in the world.

Data and digital resources
Browse our databases which house a range of plant and fungal information on naming, plants, seeds, fungi and more.
Research facilities
From laboratories to our Millennium Seed Bank, we have a wide range of state-of-the-art platforms that support the delivery our scientific research.
Find a scientist
Find out more about plant and fungal experts in our departments
Get involved with Kew Science

Global partnerships
We collaborate with over 400 institutions to deliver the greatest benefits to science, conservation policy and education.

Education and training
We offer a range of opportunities to study with us, from internships and an MSc programme, to PhDs and professional development.

Engage with Kew Science
Get involved and be a part of Kew's scientific research. Visit our collections, take part in our work and find out about the many ways you can support Kew's mission.
Digitising Kew's Collections
We've now digitised over half of our collection! See more updates from our ambitious project to digitise over 8 million specimens





